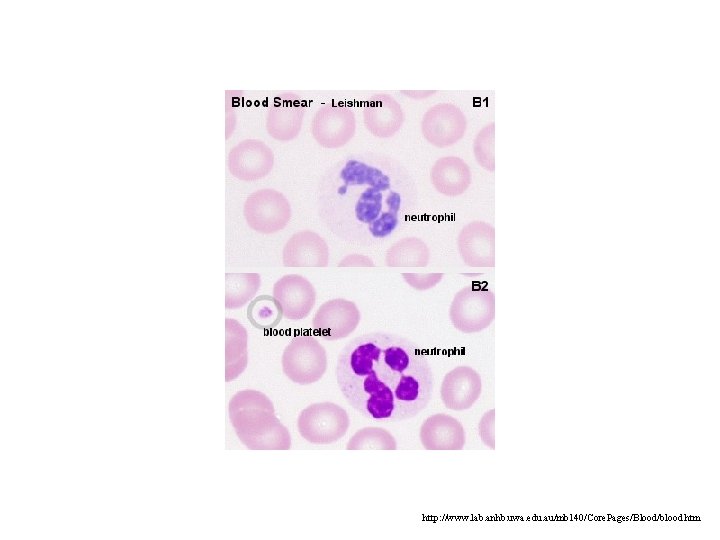
http: //www. lab. anhb. uwa. edu. au/mb 140/Core. Pages/Blood/blood. htm http: //www. lab. anhb. uwa. edu. au/mb 140/Core. Pages/Blood/blood. htm

Overview of the Immune System Chapter 1 Immunology

- Slides: 30
Overview of the Immune System Chapter 1
Immunology • The Study Of Immune System • Latin Word immunis=“exempt” • Earliest Written Reference was Thucydides 430 BC • Pasteur Was First To Successfully Apply Vaccination
Pasteur Observing Rabies Vaccination
Humoral Or Cellular Immunity? • Pasteur Did Not Know How Vaccination Worked • Behring and Kitasato (1890) Proposed Serum Was Responsible For Immunity • Elvin Kabat (1930), gamma-globulin, Antibody • Antibodies Were Present in Body Fluids=Humor • Therefore: Humoral Immunity
Innate (Non-Specific) Immunity • Innate Immunity Made Up Of 4 Forms • Anatomical, physiological, phagocytic and inflammatory • Anatomical: skin, epidermis (densely packed dead cells) • Flow of Mucus Prevents Bacterial Entry By Washing Them Away • Normal Flora Colonize Epithelial Cells Of Mucosal Surfaces, Pathogens Compete With Them For Attachment Sites
Cell Mediated Immunity • In 1883 Ellie Metchnikoff Showed That Cells Responsible For Immune State • Phagocytes More Active In Immune Animals • She Hypothesized That Cells Responsible For Immunity, Not Serum Components • Controversy Developed But Humoral School Prevailed Till 1940 • Merrill Chase Expt (1940) with Tuberculosis Infected Animals, Immunity Thru White Blood Cell Transfers
Innate (Non-Specific) Immunity • Physiologic Barriers – p. H (stomach) – Temperature (fever) – Soluble Factors (interferons, lysozyme) • Phagocytic Barriers – Specialized Cells Perform Most Of Phagocytosis (macrophages, neutrophils)
Innate (Non-Specific) Immunity • Inflammatory Barriers – Vasodilation – Cappillary permeability – Leukocyte Infiltration • Chemotactic means • Increased Adherence • Leaky capillaries
E-coli Adhering to Urinary Epithelial Cells
Chemical Mediators Of Inflammation • C-Reactive Protein (liver) • Histamine (vasodilation, increased permeability • Kinins – Small peptides normally inactive in blood – Ex. Bradykinin (causes pain)
Innate and Adaptive Immunity Collaborate • Close collaboration – Macrophages can secret cytokines that affect the type of adaptive immunity • Macrophages/DCs Present Antigen • Lymphocytes Increase Effectiveness of Macrophages
Adaptive Immunity • 4 Characteristics – Memory – Diversity – Antigenic Specificity – Self/nonself recognition
Cell Frequency of Different Leukocytes in Healthy Individuals ~ 60% neutrophils (50% - 70%) ~ 3% eosinophils (>0% - 5%) ~ 0. 5% basophils (>0% - 2%) ~ 5% monocytes (1% - 9%) ~ 30% lymphocytes (20% - 40%)
http: //www. lab. anhb. uwa. edu. au/mb 140/Core. Pages/Blood/blood. htm
http: //www. lab. anhb. uwa. edu. au/mb 140/Core. Pages/Blood/blood. htm
http: //www. lab. anhb. uwa. edu. au/mb 140/Core. Pages/Blood/blood. htm
Cells Of The Immune System • Lymphocytes – B cells, mature in Bone Marrow (CD 19, CD 20) • in periphery they express a unique surface antibody • Plasma cells differentiated B cell, short lifespan, antibody factory • Memory B cell (CD 45 RO), long life span
Cells Of Immune System • T cells, mature in Thymus (CD 3, CD 4, CD 8) • • • Two Major subsets, TH (CD 4) and TC (CD 8) Third type TS not as clear Mature T cell expresses TCR cannot recognize antigen on its own MHC I (all nucleated cells) or MHC II (APCs) is required • TH cells secrete cytokines • TC less cytokines, more cytotoxic (virus and tumor survailance)
Cells Of Immune System • Antigen Presenting Cells • Number of Cells capable of Antigen Presentation • Dendritic Cell (DC) professional APC • Macrophages, B cells • Besides Antigen They Provide Costimulation • APCs are a safeguard against autoimmunity
APC INTERACTING WITH T CELL
Specificity and Diversity • B cells are specific, 100, 000 identical antibodies on 1 B cell • 108 different B Cells in Bone Marrow, Enormous Diversity • Reduction To Avoid Auto-antibodies • Same for T Cells, Elimination in Thymus
Major Histocompatibility Complex (MHC) • • Genetic Complex With Multiple Loci MHC I - CTLs MHC II - TH MHC I+ 2 -microglobulin – 3 classes A, B, C (human) – 2 classes K and D (mouse) • MHC II – 3 classes DP, DQ, DR (human) – 2 classes IA, IE (mouse) • Highly Polymorphic in Humans
Processing and Presentation of Antigens • First Protein Antigens Must Be Broken Down • Form Complexes With MHC I or II • Exogenous Antigens – – Antigens Processed Thru Endocytic Pathway Binding of Ags To MHC II Expression of MHC II+Ags On Surface CD 4 T Cells Recognize Ag Thru Class II MHC • Endogenous Antigens – – Antigens Processed Thru Cytosolic Pathway Produced Within Cell, Ex. Virus Ag, Cancer Ag MHC I Molecules Bind Ag in ER CD 8 T Cells Recognize Ag Thru MHC I
Processing and Presentation of Antigens
Clonal Selection of Lymphocytes and Memory • Ag Reactivity Determines Clonal Expansion • Immunologic Memory is By-product of Clonal Expansion • Humoral Primary Response – 7 Days Before Antibody Levels Rise – Antibody Titer is Low Compared to Secondary • Humoral Secondary Response – 1 -2 Days Antibodies Are Detected – Antibody Titer Higher (100 -1000 fold higher) – Lasts Longer
Clonal Selection of Lymphocytes and Memory • Cell Mediated Response (TH or CTL) is Similar – Primary Response 10 -14 Days For Skin Rejection – Secondary Response Starts Immediately
Aberrant Respones – Allergy, Asthma, Anaphylaxis ØAsthma/Allergies Attacks Are Very Common ØMediated Thru Ig. E ØIg. E Binds Mast Cells, Basophils ØRe-exposure Cross Links Ig. E ØCauses Degranulation, Histamine, prostanoids